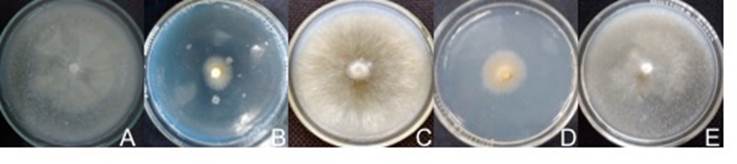

Introduction
The demand for wild edible mushrooms has increased considerably as they represent a new food trend (Martínez-Carrera, Morales, Sobal, Bonilla, & Martínez, 2007). Fungi have high nutritional and energetic value and provide health benefits, which is why they are considered functional foods of high culinary value (Trigos & Suárez-Medellín, 2010).
Mexico is one of the countries with the greatest diversity of wild edible mushrooms; about 371 species are consumed (Garibay-Orijel & Ruan Soto, 2014). Due to this great fungal diversity, it is essential to study the native wild species, strengthen their conservation and seek alternative uses (Gaitán-Hernández & Salmones, 2015). The study of wild edible mushrooms can generate great economic, social, technological and scientific benefits. Fungi represent an alternative means of helping achieve food security (Mayett & Martínez-Carrera, 2010; Organización de las Naciones Unidas para la Alimentación y la Agricultura [FAO], Fondo Internacional de Desarrollo Agrícola [FIDA], & Programa Mundial de Alimentos [PMA], 2006); their strains may be susceptible to culture (Carreño-Ruiz, Capello-García, Gaitán-Hernández, Cifuentes-Blanco, & Rosique-Gil, 2014), they boost small farmer production and they decrease dependence on foreign strains (Morales et al., 2010). Fungal germplasm could provide better resistance to attack by pests and diseases common in industrial production (Salmones, Ballesteros, Zulueta, & Mata, 2012) and generate greater competition in the market throughout the year. This resource has not been used to its full potential (Garibay-Orijel et al., 2009) and the traditional and ecological knowledge that exists in this respect can be used to identify the most valued species with the greatest demand, which may eventually be taken advantage of (Burrola-Aguilar, Montiel, Garibay-Orijel, & Zizumbo-Villarreal, 2012).
A total of 77 species of edible mushrooms have been recorded in the Nevado de Toluca Flora and Fauna Protection Area in the State of Mexico (Franco-Maass, Burrola-Aguilar, & Arana-Gabriel, 2012), some considered with high potential for culture because they are saprobes (Arana-Gabriel, Burrola-Aguilar, Garibay-Orijel, & Franco-Maass, 2014). Among the species that stand out in the region, and which are valued for food and cultural reasons, are Gymnopus dryophilus (Bull.) Murrill 1916, popularly known as “clavitos de llano”, and Lycoperdon perlatum Pers. 1796 or “terneritas” (Franco-Maass et al., 2012). The latter has great medicinal potential due to its cicatrizant, antioxidant and antimicrobial properties (Alvarado-Castillo, Mata, & Benítez-Badillo, 2015).
In recent years, research has focused on the biotechnological development of wild mushrooms at strain and inoculum levels (Martínez-Carrera et al., 2007), including studies on: mycelial growth on enriched solid culture media (Gaitán-Hernández, 2000; Gaitán-Hernández & Báez-Rodríguez, 2008; León-Avendaño, Martínez-García, Caballero, & Martínez-Carrera, 2013); influence of the liquid medium’s inoculum nutrients on the production of biomass and other metabolites (Chegwin & Nieto 2013; Lin & Chen, 2007; Torres- López, Quinter, & Tehortua, 2011); mycelial growth on different seeds (Arana-Gabriel et al., 2014; Carreño-Ruiz et al., 2014; Villegas, 2007); supplemented seeds used as inoculum (Gaitán-Hernández, Cortés, & Mata, 2014; Gaitán-Hernández & Salmones, 2015; Mata, Savoie, Delpech, & Olivier, 1998) and quantification of biomass present in inoculum prepared with seed using indirect techniques such as the estimation of fluorescein diacetate (FDA) (Mata, Ortega, & Pérez-Merlo, 2011). These studies allow us to know the nutritional and environmental requirements of the species, thereby establishing the parameters for their culture (Arana-Gabriel et al., 2014).
Based on the above, the aim of this work was to evaluate and characterize the mycelial growth of some strains of saprobic wild edible mushrooms from the central Mexican highlands, to establish the optimum conditions of in vitro mycelial culture and identify which can be susceptible to culture.
Materials and methods
Sampling area
Cacalomacán Ejidal Ecological Park (PEEC for its initials in Spanish) is located in the Nevado de Toluca Flora and Fauna Protection Area in the State of Mexico. The PEEC covers a total area of 244 ha in the 2 800 to 3 247 m altitudinal gradient. The predominant climate is temperate semi-cold with summer rains. Average annual temperature ranges between 12 and 18 °C and average annual rainfall is from 1 200 to 1 800 mm. The predominant vegetation type corresponds to a secondary coniferous forest consisting of Cupressus lindleyi Klotzsch ex Endl., Eucalyptus globulus Labill., Pinus ayacahuite C. Ehrenb. ex Schltdl., P. patula Schltdl. & Cham. and P. montezumae D. Don in Lamb. (Sánchez-Jasso, Aguilar-Miguel, Medina-Castro, & Sierra-Domínguez, 2013).
Strain collecting
By means of preferential sampling, conducted during field trips throughout the PEEC, fruit bodies were collected from saprobic fungi of cultural, alimentary and economic importance in central Mexico. The specimens were characterized macroscopically according to Delgado, Villegas, and Cifuentes (2005) and microscopically according to Franco-Maass et al. (2012) for later taxonomic identification. The specimen vouchers were deposited in the Fungal Collection (XAL) of the Institute of Ecology, a non-profit organization.
Vegetative isolation and characterization of strains
Pure cultures were obtained from fruit bodies in three commercial solid culture media (potato dextrose agar [PDA] pH 5.6, malt extract agar [MEA] pH 4.7, Sabouraud dextrose agar [SA] pH 5.6) and two unconventional media: maize agar (MA: 15 g·L-1 of corn meal, 15 g·L-1 of agar agar, 2 g·L-1 of yeast extract and 1 g·L-1 of gelatine peptone, pH 6.3) and pine needle agar (NA: 15 g·L-1 of an aqueous infusion of dried and ground pine [Pinus patula] needles, 15 g ·L-1 of agar agar, 2 g·L-1 of yeast extract and 1 g·L-1 of gelatine peptone, pH 5.8). The media were pre-sterilized at 120 °C and 15 psi for 15 min. Strains were characterized macroscopically and microscopically according to Cruz-Ulloa (1995).
Evaluation of mycelial growth in solid medium
Mycelial growth rate
With a 0.5-cm-diameter punch, mycelium was taken from the culture media in which each strain had the best mycelial development and was placed in the center of a 9-cm-diameter Petri dish. The dishes were incubated in the dark at 18 and 25 °C. For each strain, four culture media were evaluated at two temperatures, with eight replicates. Mycelial growth was measured every other day for 28 days. The measurements of each replicate were plotted against the incubation time and the growth curve was linearized to obtain the equation of a straight line (Gaitán-Hernández & Báez-Rodríguez, 2008):
Biomass quantification
The mycelium was placed in water at approximately 90 °C and rinsed until agar-free. Subsequently, the sample was placed in an oven at 80 °C for 24 h and the dry biomass was weighed (Santiago-Martínez, Estrada-Torres, Varela, & Herrera, 2003).
Evaluation of mycelial growth in seed treatments used as an inoculum source
Invasion and mycelial density
The strains G. dryophilus and L. perlatum were inoculated in four treatments: wheat (T1), sorghum (T2), wheat supplemented with 10 % pine needles (T3) and sorghum supplemented with 10 % pine needles (T4). The grains were cleaned and hydrated, after which the previously hydrated pine needles were added. Then 200 g of substrate were placed in 400-mL glass vials, with eight replicates per treatment. The vials were sterilized and incubated in the dark at 18 °C for 28 days. Afterwards, the percentage of grain invaded by the fungus and mycelial density were obtained through the qualitative analysis proposed by Villegas (2007) and modified by Arana-Gabriel et al. (2014).
Mycelial growth rate in seed
The treatment with the best invasion percentage and mycelial density was identified and 24 g fresh weight were taken to fill each 9-cm-diameter Petri dish, with 10 replicates. The dishes were inoculated with a 0.7-cm piece of mycelium in solid medium and incubated in the dark for 21 days at 20 °C. Subsequently, GR was calculated using the linear growth function described above (Gaitán-Hernández & Salmones, 2015).
Metabolic activity (Ma) of the mycelium in seed
Forty grams of seed from the optimal treatment of each strain were incubated separately in 100-mL glass vials in the dark at 20 °C. Subsequently, Ma was estimated by four weekly measurements of FDA hydrolysis according to the method of Swisher and Carrol (1980) modified by Mata and Savoie (1998).
Mycelial growth rate and biomass quantification from liquid culture
The liquid culture medium was made with 15 g of corn flour in a flask filled to 1L with distilled water. Subsequently, the medium was centrifuged in 50-mL tubes at 8 500 rpm for 10 min to obtain a precipitate-free medium. Finally, 2 g·L-1 of yeast extract and 1 g·L-1 of soy peptone were added. Then 100 mL of medium were added into 150-mL Erlenmeyer flasks and sterilized (Chegwin & Nieto 2013). The flasks were inoculated with a 0.7-cm piece of mycelium in solid media, capped with aluminum foil and placed on an orbital shaker at 80 rpm for 21 days at 20 °C. The biomass was quantified by dry weight weekly with three replicates per measurement. GR was obtained from the Monod equation as a function of biomass (Sánchez & Royse 2002):
Statistical analysis
The interaction between temperature and solid culture media on mycelial growth rate and biomass was determined using a multifactorial statistical analysis with 95 % confidence (P ≤ 0.05). Tukey’s range test was performed with the STATGRAPHICS Centurion XVI software program (Statpoint Technologies, Inc., 2009), to know the statistically significant differences in the mean values.
Results and discussion
Obtaining and microscopic and macroscopic characterization of strains
Five strains of wild edible mushrooms were isolated in pure culture in vitro: Bovista aestivalis (Bonord.) Demoulin 1979 (pedo de burro), Infundibulicybe squamulosa (Pers.) Harmaja 2003 ( tejamanilero or copa), I. gibba (Pers.) Harmaja 2003 (tejamanil), G. dryophilus (clavitos de llano) and L. perlatum (terneritas). The strains were safeguarded in the fungal strain collection of the Institute of Ecology, under the numbers: IE 991 (B. aestivalis), IE 988 (G. dryophilus), IE 989 (I. gibba), IE 990 (I. squamulosa) and IE 987 (L. perlatum).
The fungus B. aestivalis was able to develop in all media with a GR of 1.2 mm·d-1, although the growth in SA and MEA, at 18 and 25 °C, was slow and sparse. The mycelium has an irregular, circular shape with a fimbriated margin, a velvety texture with a flat surface and white prostrate-submerged growth (Figure 1A). The hyphae are sinuous with hyaline, rounded ends and measure 1.1 (0.7-2.4) mm wide.
Figure 1 Mycelium of the strains obtained. A) Bovista aestivalis in maize agar (MA) at 18 °C, B) Infundibulicybe gibba in PDA at 25 °C, C) Gymnopus dryophilus in pine needle agar at 18 °C, D) Infundibulicybe squamulosa in MA at 18 °C and E) Lycoperdon perlatum in MA at 18 °C.
Infundibulicybe gibba grew in all media and at both temperatures with a GR of 1.0 mm·d-1; however, in NA it presented the lowest growth and density. The mycelium has a circular shape with a smooth, fimbriated margin, a velvety texture, a flat surface and submerged growth (Figure 1B). The hyphae measured 2.2 (1.5-2.8) (m wide, and are smooth with hyaline, rounded-globose ends, with fibulae and parietal extensions.
Gymnopus dryophilus had a GR of 2.2 mm·d-1 and high mycelial density in all media under the two evaluation temperatures, with the exception of SA at 18 and 25 °C where growth was very slow. The mycelium is circular-shaped with a fimbriated margin, cottony texture and flat surface; the growth is aerial and white, which with aging changes to a creamy brown hue (Figure 1C). The hyphae are smooth with septate, hyaline, rounded ends; it has abundant fibulae and parental extensions. The hyphae measured 3.1 µm wide in MA, 3.9 mm in NA, 3.1 mm in MEA and 3.0 mm in PDA at 18 °C; and 3.4 mm wide in MA, 3.7 mm in NA, 2.7 mm in MEA and 2.7 mm in PDA at 25 °C.
Infundibulicybe squamulosa developed in all media at both temperatures; however, its GR was 0.9 mm·d-1 and its mycelial density was very low. The mycelium is yellow, submerged and irregularly-shaped with a smooth, fimbriated margin, a velvety texture and a flat surface (Figure 1D). The fungus developed hyphae measuring 2.6 (2.2-3.3) mm wide, branched, septate and with frequent fibulae.
Lycoperdon perlatum grew at a GR of 1.6 mm·d-1. In MEA at 18 and 25 °C, growth was almost nil. The mycelium is circular-shaped with a fimbriated margin, cottony texture and flat surface; the growth is creamy white, submerged-aerial (Figure 1E). The hyphae are smooth-sinuous with hyaline, rounded-globose ends, with parietal extensions and scarce fibulae. The hyphae measured 3.3 mm wide in MA, 3.7 mm in NA, 2.8 mm in SA and 2.5 mm in PDA at 18 °C; and 3.1 mm in MA, 3.4 mm in NA, 2.7 mm in SA and 2.9 mm in PDA at 25 °C.
Bovista aestivalis, I. gibba and I. squamulosa had slow growth, so only G. dryophilus was selected in NA, MA, PDA and MEA at 18 and 25 °C, and L. perlatum in NA, MA, PDA and SA at 18 and 25 °C, to evaluate mycelial growth in solid medium and in seed used as an inoculant.
Evaluation of mycelial growth in solid medium
Mycelial growth rate and biomass quantification
Table 1 reports the GR and biomass of G. dryophilus and L. perlatum in the culture media and evaluation temperatures. In this table it can be seen that there were no statistically significant differences among the treatments (P > 0.05) and that there was no interaction between the culture media and the temperature on G. dryophilus GR. Regarding biomass, there are statistical differences among the treatments and there is interaction between the culture media and the temperature (P < 0.05) on this variable. The optimal treatments were NA and MA, both at 18 and 25 °C. In the case of L. perlatum, there are statistically significant differences among the treatments and interaction between the culture media and the temperature (P < 0.05) on GR. The highest GR values were obtained in the treatments NA at 18 and 25 °C and MA at 18 °C. Concerning biomass, there are statistical differences among treatments and interaction between the culture media and the temperature (P > 0.05). MA medium at 18 °C and NA at 25 °C were the treatments with the highest biomass production.
Table 1 Mycelial growth rate (GR) and biomass production of Gymnopus dryophilus and Lycoperdon perlatum.
| Temperature (°C) | Culture medium | Gymnopus dryophilus | Lycoperdon perlatum | ||
|---|---|---|---|---|---|
| GR (mm·d-1) | Biomass (mg) | GR (mm·d-1) | Biomass (mg) | ||
| 18 | SA | NE | NE | 1.6 cd | 10 cd |
| MA | 2.2 a | 70 abc | 2.0 a | 30 a | |
| NA | 2.3 a | 110 a | 1.9 a | 10 bc | |
| PDA | 2.4 a | 30 c | 1.0 e | 6 e | |
| MEA | 2.2 a | 40 bc | NE | NE | |
| 25 | SA | NE | NE | 1.6 c | 10 c |
| MA | 2.2 a | 60 abc | 1.7 b | 10 b | |
| NA | 2.2 a | 90 ab | 2.0 a | 20 a | |
| PDA | 2.2 a | 30 c | 1.1 d | 7 d | |
| MEA | 2.3 a | 0.04 bc | NE | NE | |
SA: Sabouraud dextrose agar, MA: maize agar, NA: pine needle agar, PDA: potato dextrose agar and MEA: malt extract agar. NE: medium not evaluated. The letters in each column represent significant differences among treatments (Tukey, P < 0.05).
Gymnopus dryophilus and L. perlatum showed no differences in macroscopic characteristics among the evaluated treatments, probably due to the phenotypic characters of each strain as indicated by León-Avendaño et al. (2013). In the case of G. dryophilus, it could be because all the culture media have the necessary nutrients, so there are no interactions between temperature and culture media on GR. However, biomass is affected by the interaction between temperature and culture media (P < 0.05, Table 1). In PDA and MEA at 18 and 25 °C, mycelial density was lower, reflected in lower biomass production, in contrast to the MA medium in which very abundant aerial mycelium developed. For L. perlatum, the density and speed of mycelial growth are affected by the treatments (P < 0.05, Table 1). In this case, NA medium at 18 and 25 °C produced higher mycelial growth and density followed by MA at 18 °C (aerial mycelium in both media), while in PDA at 18 and 25 °C the lowest growth values were obtained.
The highest GR and biomass values in both species were obtained with NA and MA media, which is attributed to the NA medium being based on pine needles, giving the mycelium the conditions of their natural medium. This is consistent with the findings of Gaitán-Hernández (2000), who demonstrated that the greatest mycelial growth of Neolentinus suffrutescens (Brot.) T. W. May & A. E. Wood was obtained in medium supplemented with pine wood extract (natural medium of the fungus).
The use of the MA medium is recommended because of the ease of acquiring corn flour. Lin and Chen (2007) and Chegwin and Nieto (2013) reported that flour-based media have an ideal C/N ratio for the production of biomass and other metabolites, essential parameters for a strain to be susceptible to culture.
On the other hand, in both strains there are differences in hyphal width based on the culture medium used. The widest hyphae of G. dryophilus correspond to NA medium at 18 °C (3.9 mm), NA at 25 °C (3.7 mm), MA at 18 °C (3.1 mm) and MA at 25 °C (3.4 mm), where the GR and biomass were higher compared to PDA at 18 °C (2.9 mm) and 25 °C (2.7 mm) and MEA at 18 °C (3.0 mm) and 25 °C (2.7 mm), where mycelial growth was lower and there were even more parietal extensions. According to Harris (2008), the formation of extensions is because the mycelium seeks nutrients in the medium, being forced to generate more hyphae but of lesser thickness; this was not reflected in the mycelial growth rate, but in the production of biomass. Likewise, L. perlatum hyphae were thicker in NA at 18 °C (3.7 mm), NA at 25 °C (3.4 mm), MA at 18 °C (3.3 mm) and MA at 25 °C (3.1 mm), corresponding to the treatments where GR and biomass were higher. In SA at 18 °C (2.8 mm) and 25 °C (2.7 mm), and PDA at 18 °C (2.5 mm) and 25 °C (2.9 mm), L. perlatum hyphae were thinner and with more parietal extensions, extending apically to obtain the necessary nutrients (Sánchez & Royse, 2002).
Another factor of utmost importance is the pH of the media. The fungus G. dryophilus showed a lower GR and biomass in treatments with lower pH (MEA = 4.7 and PDA = 5.6) compared to MA = 6.3 and NA = 5.8, suggesting that the optimum pH is within this range. In the same way, L. perlatum had better mycelial development in MA = 6.3 and NA = 5.8, and the lowest values were obtained in PDA = 5.6, SA = 5.6 and even MEA = 4.7, where growth was almost nil. This indicates that the optimum pH for this species is also closer to neutral pH.
Evaluation of mycelial growth in seed used as an inoculum source
Invasion and mycelial density in seed
The density of G. dryophilus mycelium incubated at 18 °C in wheat (T1, 30 % moisture and pH 7.0) was 3.4 with 90 % invasion, and in sorghum (T2, 20% humidity and pH 7.3) the mycelial density was 3.2 with 90 % invasion (Figure 2A); in both cases, the mycelium was moderately dense. In wheat supplemented with pine needles (T3, 40 % moisture and pH 6.6) and in sorghum supplemented with pine needles (T4, 37% humidity and pH 6.9), the values increased considerably, obtaining a density of 4.2 and 100 % invasion in T3 and a density of 4.5 % and 100 % invasion of the grain in T4 (Figure 2B), in both cases with moderately dense mycelium.

Figure 2 Mycelium of Gymnopus dryophilus: A) sorghum seed, B) sorghum seed supplemented with pine needles. Mycelium of Lycoperdon perlatum in: C) sorghum seed, D) sorghum seed supplemented with pine needles.
In L. perlatum, the density of mycelium incubated at 18 °C in wheat (T1) and sorghum (T2, Figure 2C) was very low with an almost zero invasion percentage, corresponding to low density mycelium. By contrast, in supplemented wheat (T3) and supplemented sorghum (T4), mycelial density was 4.5 with 100 % mycelial invasion for T3, and a density of 4.8 and 100 % invasion of the grain for T4 (Figure 2D), both cases with moderately dense mycelium.
Regarding the invasion percentage and mycelial density in seed as an inoculum source, for both G. dryophilus and L. perlatum, the T4 treatment at 18 °C was the optimum one. This may be because pine needles provide a higher moisture percentage to the T3 and T4 treatments. Thus, there is a greater availability of water for the mycelium; additionally, the supplemented grain has pH (6.9) close to the optimum for mycelial development in solid medium.
Metabolic activity and mycelial growth rate in seed
Because G. dryophilus and L. perlatum showed better mycelial development in supplemented sorghum, the treatments comprising sorghum (T2) and sorghum supplemented with needles (T4) at 18 °C were used to estimate the metabolic activity (Ma) of the strains and contrast the mycelial development in a supplemented and non-supplemented substrate.
The G. dryophilus mycelium presented an approximately 21-day latency phase in T2 (Figure 3A). After this period, the exponential phase reached values of 71.07 (g of hydrolyzed FDA·g-1 of dry substrate. By contrast, G. dryophilus exhibited metabolic activity from the first week in T4, maintaining its growth until the third week with Ma of 61 (g of hydrolyzed FDA·g-1 of dry substrate and a GR of 1.18 mm·d-1.

Figure 3 Metabolic activity (Ma) determined by fluorescein diacetate (FDA) hydrolysis: A) Gymnopus dryophilus in sorghum (T2) and sorghum supplemented with pine needles (T4); B) Lycoperdon perlatum in sorghum (T2) and sorghum supplemented with pine needles (T4).
Lycoperdon perlatum showed low Ma of 6.9 (g of hydrolyzed FDA·g-1 of dry substrate in T2 (Figure 3B) and, therefore, very low biomass production. In T4, L. perlatum had higher metabolic activity of 23.6 (g of hydrolyzed FDA·g-1 of dry substrate, because the supplemented substrate provided better conditions for mycelial development (37 % moisture and pH 6.9), although the exponential phase of the mycelium began after 21 days of incubation. The GR in T4 was 0.68 mm·d-1.
In Figure 3A it can be seen that there is a decline in the Ma of G. dryophilus from 21 days in T4. This does not represent a cell death phase but rather denotes that its energy expenditure is focused on metabolic functions different from biomass production, such as, possibly, the preparation of the mycelium for fruiting, as mentioned by Mata et al. (2011). The fungus G. dryophilus secretes exudates due to the addition of needles; Gaitán-Hernández et al. (2014) attribute this to the fact that the mycelium is in a mature state and ready for fruiting, in contrast to T2 where after 21 days of incubation the exponential production of biomass begins. Due to the above, it is considered that the supplemented sorghum (T4) at 18 °C is the optimal treatment for the production of G. dryophilus inoculum.
Lycoperdon perlatum showed very low Ma in both treatments. In T2 this is possibly due to the fact that the moisture conditions (20 %) are very low, and that the pH (7.3) is above the optimum (6.3) for the development of the strain, thereby inhibiting the development of the mycelium. The fungus L. perlatum was able to reach higher Ma values in T4 during a longer incubation period; however, biomass and GR values are too low to consider this treatment as an option for inoculum production.
According to Villegas (2007), seeds provide a high content of carbohydrates and proteins that allow for good mycelial development; however, the mycelial growth and biomass production of G. dryophilus and L. perlatum were greater in seeds supplemented with pine needles. This is attributed to the fact that needles are the natural medium of fungi, so they are adapted to grow in it. Mata et al. (2011) indicate that the mycelium could produce lignocellulolytic enzymes that give it the capacity to properly exploit the nutrients in the substrate, thus facilitating its growth; Gaitán-Hernández and Salmones (2015) also report the presence of chemical elements that favor greater enzymatic activity of the fungus. The rapid invasion of the mycelium on the grain is of utmost importance for the optimization of culture processes (Gaitán-Hernández & Salmones, 2015), so it is recommended to use the seed inoculum supplemented with pine needles. In addition, by supplementing the seed with compounds of complex organic structures, contamination by other fungi decreases significantly (Mata et al., 1998).
Mycelial growth rate in liquid culture
The medium used had pH 7.27. The fungus G. dryophilus had a GR of 0.11 g of dry biomass·d-1, reaching 7.3 g of centrifuged fresh biomass. Lycoperdon perlatum presented a GR of 0.12 g of dry biomass d-1 and 2.4 g of centrifuged fresh biomass.
The amount of G. dryophilus biomass in liquid culture is significant because the greatest effect is exerted by the available carbon source in corn flour (Torres-López et al., 2011). In spite of this, it is recommended to use seed as an inoculation source, since it is more accessible, specialized equipment is not needed for preparing it and it is more economical (Sánchez & Royse, 2002); in additon, it has the capacity to inoculate a greater amount of substrate. By contrast, for L. perlatum it is recommended to use liquid culture for its production, since the biomass and GR obtained with the seed are very low and it is not feasible to develop inoculum at a larger scale.
Conclusions
Mycelial growth of Bovista aestivalis, Infundibulicybe squamulosa, I. gibba, Gymnopus dryophilus and Lycoperdon perlatum, in solid medium, was higher in unconventional media such as corn agar and pine needle agar at 18 °C. Gymnopus dryophilus and L. perlatum showed higher invasion, density, growth rate and mycelial biomass production values in sorghum seeds supplemented with 10 % pine needles, used as an inoculation source, than in grains without supplementation; in addition, the incubation time was lower. In the case of L. perlatum it is possible to use liquid culture for its production, since the biomass and growth rate in sorghum were very low and it is not feasible to develop inoculum at a greater scale. The G. dryophilus strain is susceptible to culture; the optimal conditions are found in flour-based solid media and in sorghum supplemented with pine needles at approximately 18 °C and near-neutral pH. According to the evaluation of mycelial growth and in the absence of similar studies, the results should serve as a basis for further studies on in vitro culture of the five species from the central Mexican highlands.











 texto en
texto en 


